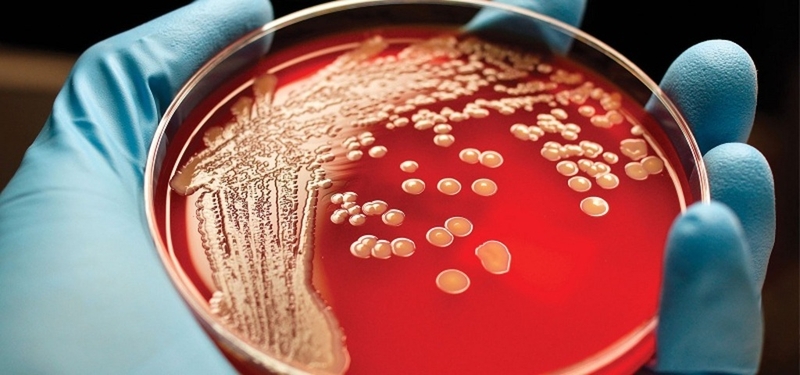
Những thông tin cơ bản về kỹ thuật xét nghiệm dịch ngoáy họng 4

Tốt nghiệp Đại học Dược Hà Nội, với hơn 10 năm kinh nghiệm trong lĩnh vực Dược phẩm. Hiện là giảng viên giảng dạy các môn Dược lý, Dược lâm sàng,...
Ánh Vũ
20/06/2024
Mặc định
Lớn hơn
Các vi sinh vật vùng họng miệng và họng mũi sẽ phát triển và gây bệnh cho cơ thể khi hệ thống miễn dịch bị suy yếu hoặc khi niêm mạc bị tổn thương. Trong bài viết hôm nay, Nhà thuốc Long Châu sẽ chia sẻ đến bạn đọc những thông tin cơ bản về xét nghiệm dịch ngoáy họng - một trong những phương pháp hỗ trợ chẩn đoán bệnh trong y khoa.
Xét nghiệm dịch ngoáy họng là một trong những phương pháp hữu hiệu, có ý nghĩa rất lớn trong phát hiện và chẩn đoán bệnh. Vậy xét nghiệm này được chỉ định trong những trường hợp nào? Quy trình thực hiện ra sao? Ý nghĩa của xét nghiệm này trong lâm sàng cụ thể như thế nào? Cùng Nhà thuốc Long Châu làm sáng tỏ trong bài viết hôm nay nhé.
Xét nghiệm dịch ngoáy họng giúp xác định sự tồn tại của vi khuẩn gây bệnh, thường được các bác sĩ chỉ định trong các trường hợp:

Về cơ bản, kỹ thuật xét nghiệm dịch ngoáy họng được tiến hành lần lượt theo các bước sau:
Để thực hiện xét nghiệm dịch ngoáy họng, dụng cụ cần chuẩn bị bao gồm:
Chuẩn bị cho bệnh nhân gồm có:

Mẫu bệnh phẩm là dịch ngoáy họng, cần được lấy trước khi người bệnh sử dụng kháng sinh toàn thân. Mẫu bệnh phẩm của xét nghiệm có thể được lấy thông qua 2 con đường đó là đường họng miệng và đường họng mũi. Cụ thể:
Đối với đường miệng họng:
Đối với đường mũi họng:

Xét nghiệm dịch ngoáy họng bao gồm:
Xét nghiệm soi trực tiếp
Xét nghiệm soi trực tiếp thông qua nhuộm Gram khi bác sĩ chỉ định tìm vi khuẩn dạng xoắn khuẩn, bạch hầu hoặc nấm men. Ngoài ra, nhuộm xanh Methylen kiềm được thực hiện khi bác sĩ chỉ định tìm vi khuẩn bạch hầu. Sau khi phát hiện hình thể vi khuẩn điển hình, các kỹ thuật viên sẽ cho ra kết quả sơ bộ để dựa vào đó bác sĩ có thể đưa ra hướng điều trị kịp thời.
Xét nghiệm nuôi cấy, phân lập và định danh
Nuôi cấy dịch ngoáy họng để xác định sự tồn tại của liên cầu khuẩn nhóm A. Đối với phương pháp này, dịch ngoáy họng sẽ được nuôi cấy trong các môi trường thích hợp như môi trường trứng, môi trường có Tellurite, đặt trong tủ ấm ở nhiệt độ 35 - 37 độ C có 5% CO2 trong 18 - 48 giờ. Chọn khuẩn lạc điển hình để khảo sát tính chất về hình thể, sinh hoá và các định độc tố của vi khuẩn gây bệnh.
Phương pháp miễn dịch học thử nghiệm hoá miễn dịch
Phương pháp miễn dịch học bao gồm ELISA, tụ latex hoặc sắc ký miễn dịch. Phương pháp này được thực hiện nhằm mục đích tìm kháng nguyên đặc hiệu liên cầu huyết beta nhóm A. Trong 3 phương pháp nêu trên thì phương pháp sắc ký miễn dịch và tụ latex được đánh giá là có độ nhạy và độ đặc hiệu cao hơn, dễ thực hiện tại các phòng khám.
Trên thực tế, không ai có thể phủ nhận được ý nghĩa của xét nghiệm dịch ngoáy họng trong phát hiện và chẩn đoán bệnh, đặc biệt là bệnh về đường hô hấp. Theo đó:
Phương pháp miễn dịch học thử nghiệm hoá miễn dịch giúp phát hiện nhanh liên cầu tiêu huyết nhóm A trong mẫu phết họng. Các thử nghiệm này có độ nhạy và độ đặc hiệu cao, không thua kém nuôi cấy và đặc biệt là dễ dàng thực hiện tại các phòng khám, cho kết quả nhanh chóng chỉ trong vòng 10 phút. Điều này có ý nghĩa rất lớn trong việc giúp bác sĩ đưa ra được hướng điều trị và điều trị chính xác ngay từ đầu.
Nuôi cấy là một trong những phương pháp xác định chính xác sự tồn tại của liên cầu huyết nhóm A trong mẫu phết họng. Thông qua phương pháp này, bác sĩ sẽ đưa ra được chính xác về loại vi khuẩn đích đã định danh cùng kết quả kháng sinh đồ liên cầu nhóm A.
Trên đây là toàn bộ những thông tin cơ bản xoay quanh xét nghiệm dịch ngoáy họng mà Nhà thuốc Long Châu muốn chia sẻ đến bạn đọc trong bài viết hôm nay. Hy vọng, qua bài viết này, bạn đọc sẽ có thêm nhiều thông tin hữu ích và hiểu rõ hơn về kỹ thuật này. Cảm ơn bạn đã luôn tin tưởng và dõi theo Nhà thuốc Long Châu.
Dược sĩ Đại họcNguyễn Thanh Hải
Tốt nghiệp Đại học Dược Hà Nội, với hơn 10 năm kinh nghiệm trong lĩnh vực Dược phẩm. Hiện là giảng viên giảng dạy các môn Dược lý, Dược lâm sàng,...